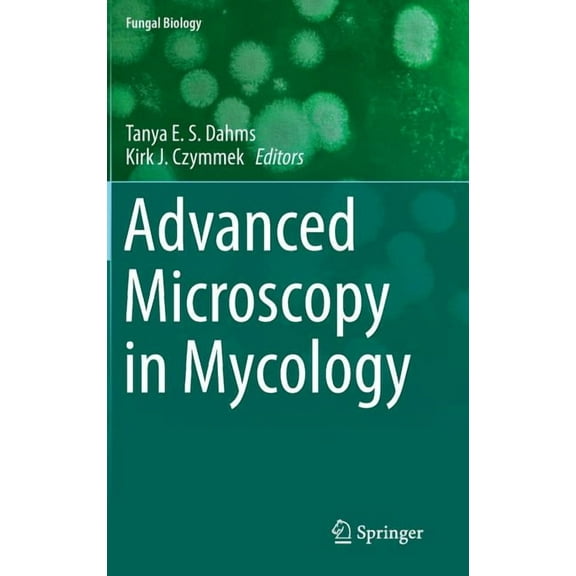
Fungal Biology Advanced Microscopy in Mycology, (Hardcover)

CRC Marine Biology The Biology of Sea Turtles, Volume 3, (Hardcover)
Key item features
- CRC Marine Biology The Biology of Sea Turtles, Volume 3, (Hardcover)
- Author: CRC Press
- ISBN: 9781439873076
- Format: Hardcover
- Publication Date: 2013-03-25
- Page Count: 475
Specs
- Book formatHardcover
- Fiction/nonfictionNon-Fiction
- GenreTravel & Nature
- Pub date2013-03-25
- Pages475
- SubgenreAnimals
- Free shipping
Free 90-day returns
How do you want your item?
More seller options (2)
About this item
Product details
Since the first volume of The Biology of Sea Turtles was published in 1997, the field has grown and matured in ways few of the authors would have predicted--particularly in the areas of physiology, behavior, genetics, and health. Volume III presents timely coverage of emerging areas as well as the integration of approaches and information that did not exist even a decade ago. The book assembles the foremost experts in each topic to provide the most up-to-date and comprehensive book on sea turtles available today.
New areas covered include in vivo imaging of structure, spatial distributions of marine turtles at sea, epibiosis, imprinting, parasitology, and climatic effects. Life history is explored in three chapters covering age determination, predator-prey interactions, and mortality from bycatch.
The Biology of Sea Turtles, Volume III will inspire scientists and students to explore and expand their understanding of these intriguing animals. The book provides clear baseline summaries, thoughtful syntheses, and effective presentation of the most fundamental topics spanning form and function, health, distributions, behavior, genetics, evolution, and ecology. Its scope and depth make it the definitive go-to reference in the field.- CRC Marine Biology The Biology of Sea Turtles, Volume 3, (Hardcover)
- Author: CRC Press
- ISBN: 9781439873076
- Format: Hardcover
- Publication Date: 2013-03-25
- Page Count: 475
Specifications
Book format
Fiction/nonfiction
Genre
Pub date
Warranty
Warranty information
Compare with similar items
| Product | Viewing this itemCRC Marine Biology The Biology of Sea Turtles, Volume 3, (Hardcover)  $91.00 current price $91.00 | Understanding Marine Biology, (Hardcover)  $64.13 current price $64.13 | Underwater Lives: Humans, Species, Ocean, (Hardcover)  $90.00 current price $90.00 | Ecology and Biology of Soil, (Hardcover)  $90.82 current price $90.82 | Basic and Applied Zooplankton Biology, (Hardcover)  $90.04 current price $90.04 | The Pollution Biology of Aquatic Oligochaetes, (Hardcover)  $91.97 current price $91.97 | Biomineralization, Environmental Microbiology and Earth Science, (Hardcover)  $96.06 current price $96.06 | Applied Biology and Biochemistry in Animal Science, (Hardcover)  $98.19 current price $98.19 | Biology of Marine Mammals, (Hardcover)  $91.92 current price $91.92 |
|---|
| Book format | HardcoverCRC Marine Biology The Biology of Sea Turtles, Volume 3, (Hardcover) | HardcoverUnderstanding Marine Biology, (Hardcover) | HardcoverUnderwater Lives: Humans, Species, Ocean, (Hardcover) | HardcoverEcology and Biology of Soil, (Hardcover) | HardcoverBasic and Applied Zooplankton Biology, (Hardcover) | HardcoverThe Pollution Biology of Aquatic Oligochaetes, (Hardcover) | HardcoverMarine Biology, (Hardcover) | HardcoverBiomineralization, Environmental Microbiology and Earth Science, (Hardcover) | HardcoverApplied Biology and Biochemistry in Animal Science, (Hardcover) | HardcoverBiology of Marine Mammals, (Hardcover) |
|---|---|---|---|---|---|---|---|---|---|---|
| Fiction/nonfiction | Non-FictionCRC Marine Biology The Biology of Sea Turtles, Volume 3, (Hardcover) | Non-FictionUnderstanding Marine Biology, (Hardcover) | Non-FictionUnderwater Lives: Humans, Species, Ocean, (Hardcover) | Non-FictionEcology and Biology of Soil, (Hardcover) | Non-FictionBasic and Applied Zooplankton Biology, (Hardcover) | Non-FictionThe Pollution Biology of Aquatic Oligochaetes, (Hardcover) | Non-FictionMarine Biology, (Hardcover) | Non-FictionBiomineralization, Environmental Microbiology and Earth Science, (Hardcover) | Non-FictionApplied Biology and Biochemistry in Animal Science, (Hardcover) | Non-FictionBiology of Marine Mammals, (Hardcover) |
| Genre | Travel & NatureCRC Marine Biology The Biology of Sea Turtles, Volume 3, (Hardcover) | TextbooksUnderstanding Marine Biology, (Hardcover) | Biography & MemoirsUnderwater Lives: Humans, Species, Ocean, (Hardcover) | Computing & InternetEcology and Biology of Soil, (Hardcover) | Computing & InternetBasic and Applied Zooplankton Biology, (Hardcover) | TextbooksThe Pollution Biology of Aquatic Oligochaetes, (Hardcover) | TextbooksMarine Biology, (Hardcover) | TextbooksBiomineralization, Environmental Microbiology and Earth Science, (Hardcover) | TextbooksApplied Biology and Biochemistry in Animal Science, (Hardcover) | TextbooksBiology of Marine Mammals, (Hardcover) |
| Pub date | 2013-03-25CRC Marine Biology The Biology of Sea Turtles, Volume 3, (Hardcover) | April 1, 2010Understanding Marine Biology, (Hardcover) | 2026-06-25Underwater Lives: Humans, Species, Ocean, (Hardcover) | 20180524Ecology and Biology of Soil, (Hardcover) | August 8, 2018Basic and Applied Zooplankton Biology, (Hardcover) | 2011-08-31The Pollution Biology of Aquatic Oligochaetes, (Hardcover) | January 1, 2013Marine Biology, (Hardcover) | 2016-06-02Biomineralization, Environmental Microbiology and Earth Science, (Hardcover) | 2016-05-31Applied Biology and Biochemistry in Animal Science, (Hardcover) | 2017-06-28Biology of Marine Mammals, (Hardcover) |
Similar items you might like
Based on what customers bought
Understanding Marine Biology, (Hardcover) $64.13
 $6413current price $64.13
$6413current price $64.13Understanding Marine Biology, (Hardcover)
Save withShipping, arrives in 3+ daysUnderwater Lives: Humans, Species, Ocean, (Hardcover) $90.00
 $9000current price $90.00
$9000current price $90.00Underwater Lives: Humans, Species, Ocean, (Hardcover)
Save withShipping, arrives by release date Jun 25Ecology and Biology of Soil, (Hardcover) $90.82
 $9082current price $90.82
$9082current price $90.82Ecology and Biology of Soil, (Hardcover)
Save withShipping, arrives in 3+ daysBasic and Applied Zooplankton Biology, (Hardcover) $90.04
 $9004current price $90.04
$9004current price $90.04Basic and Applied Zooplankton Biology, (Hardcover)
Save withShipping, arrives in 3+ daysThe Pollution Biology of Aquatic Oligochaetes, (Hardcover) $91.97
 $9197current price $91.97
$9197current price $91.97The Pollution Biology of Aquatic Oligochaetes, (Hardcover)
Save withShipping, arrives in 3+ daysMarine Biology, (Hardcover) $100.86
 $10086current price $100.86
$10086current price $100.86Marine Biology, (Hardcover)
Save withShipping, arrives in 3+ daysBiomineralization, Environmental Microbiology and Earth Science, (Hardcover) $96.06
 $9606current price $96.06
$9606current price $96.06Biomineralization, Environmental Microbiology and Earth Science, (Hardcover)
Save withShipping, arrives in 3+ daysApplied Biology and Biochemistry in Animal Science, (Hardcover) $98.19
 $9819current price $98.19
$9819current price $98.19Applied Biology and Biochemistry in Animal Science, (Hardcover)
Save withShipping, arrives in 3+ daysBiology of Marine Mammals, (Hardcover) $91.92
 $9192current price $91.92
$9192current price $91.92Biology of Marine Mammals, (Hardcover)
Save withShipping, arrives in 3+ daysMarine Biology, Ecology and Zoology, (Hardcover) $92.17
 $9217current price $92.17
$9217current price $92.17Marine Biology, Ecology and Zoology, (Hardcover)
Save withShipping, arrives in 3+ daysCRC Marine Biology The Physiology of Fishes, (Paperback) $90.00
 $9000current price $90.00
$9000current price $90.00CRC Marine Biology The Physiology of Fishes, (Paperback)
Save withShipping, arrives in 3+ daysFungal Biology Advanced Microscopy in Mycology, (Hardcover) $89.51
$8951current price $89.51
$8951current price $89.51Fungal Biology Advanced Microscopy in Mycology, (Hardcover)
Save withShipping, arrives in 3+ daysDevelopments in Environmental Biology of Ecomorphology of Fishes, Book 16, (Hardcover) $93.76
 $9376current price $93.76
$9376current price $93.76Developments in Environmental Biology of Ecomorphology of Fishes, Book 16, (Hardcover)
Save withShipping, arrives in 3+ daysDevelopments in Environmental Biology of When Do Fishes Become Juveniles?, Book 19, (Hardcover) $77.74 Was $86.83
 Now$7774current price Now $77.74, Was $86.83$86.83
Now$7774current price Now $77.74, Was $86.83$86.83Developments in Environmental Biology of When Do Fishes Become Juveniles?, Book 19, (Hardcover)
Save withShipping, arrives in 3+ daysCRC Marine Biology Hagfish Biology, (Paperback) $53.59
 $5359current price $53.59
$5359current price $53.59CRC Marine Biology Hagfish Biology, (Paperback)
Save withShipping, arrives in 3+ daysCRC Marine Biology Sharks and Their Relatives II: Biodiversity, Adaptive Physiology, and Conservation, (Hardcover) $88.09
 $8809current price $88.09
$8809current price $88.09CRC Marine Biology Sharks and Their Relatives II: Biodiversity, Adaptive Physiology, and Conservation, (Hardcover)
Save withShipping, arrives in 3+ daysOceanography and Marine Biology; 27, (Hardcover) $39.95
 $3995current price $39.95
$3995current price $39.95Oceanography and Marine Biology; 27, (Hardcover)
Save withShipping, arrives in 3+ daysOceanography and Marine Biology - An Ann Oceanography and Marine Biology: An Annual Review. Volume 48, (Paperback) $63.74
 $6374current price $63.74
$6374current price $63.74Oceanography and Marine Biology - An Ann Oceanography and Marine Biology: An Annual Review. Volume 48, (Paperback)
Save withShipping, arrives in 3+ daysSeabed Fluid Flow: The Impact on Geology, Biology and the Marine Environment, (Paperback) $79.99
 $7999current price $79.99
$7999current price $79.99Seabed Fluid Flow: The Impact on Geology, Biology and the Marine Environment, (Paperback)
Save withShipping, arrives in 3+ daysBiology and Ecology of Aquatic Animals, (Hardcover) $91.92
 $9192current price $91.92
$9192current price $91.92Biology and Ecology of Aquatic Animals, (Hardcover)
Save withShipping, arrives in 3+ days
Popular items in this category
Best selling items that customers love
Plant Cell Monographs Cell Biology of Plant Nematode Parasitism, Book 15, (Hardcover) $141.70
 $14170current price $141.70
$14170current price $141.70Plant Cell Monographs Cell Biology of Plant Nematode Parasitism, Book 15, (Hardcover)
Save withShipping, arrives in 3+ daysThe Handbook Of Nature Study in Color - Fish, Reptiles, Amphibians, Invertebrates, (Paperback) $16.99
 $1699current price $16.99
$1699current price $16.99The Handbook Of Nature Study in Color - Fish, Reptiles, Amphibians, Invertebrates, (Paperback)
Save withShipping, arrives in 3+ daysBiology of Habitats The Biology of Coral Reefs, (Paperback) $86.66
 $8666current price $86.66
$8666current price $86.66Biology of Habitats The Biology of Coral Reefs, (Paperback)
Shipping, arrives in 3+ daysNaturalist's Notebook - Hardcover $13.67
 $1367current price $13.67
$1367current price $13.67Naturalist's Notebook - Hardcover
Save withShipping, arrives in 3+ daysAdvances in Marine Biology Global Knowledge on the Commercial Sea Cucumber Holothuria Scabra: Volume 91, Book 91, (Hardcover) $167.13
 $16713current price $167.13
$16713current price $167.13Advances in Marine Biology Global Knowledge on the Commercial Sea Cucumber Holothuria Scabra: Volume 91, Book 91, (Hardcover)
Save withShipping, arrives in 3+ daysBelle Baruch Marine Science: Freshwater Fishes of South Carolina (Hardcover) $63.14
 $6314current price $63.14
$6314current price $63.14Belle Baruch Marine Science: Freshwater Fishes of South Carolina (Hardcover)
Shipping, arrives in 3+ daysOrganismic Animal Biology: An Evolutionary Approach, (Hardcover) $68.71
 $6871current price $68.71
$6871current price $68.71Organismic Animal Biology: An Evolutionary Approach, (Hardcover)
Save withShipping, arrives in 3+ daysTextbook of Marine Biology, (Hardcover) $118.90
 $11890current price $118.90
$11890current price $118.90Textbook of Marine Biology, (Hardcover)
Shipping, arrives in 3+ daysCancer Treatment and Research Endocrine Neoplasia, Book 153, (Hardcover) $117.59
 $11759current price $117.59
$11759current price $117.59Cancer Treatment and Research Endocrine Neoplasia, Book 153, (Hardcover)
Save withShipping, arrives in 3+ daysThe Classes of Higher Dimensional Polytopes in Chemical, Physical, and Biological Systems, (Hardcover) $215.00
 $21500current price $215.00
$21500current price $215.00The Classes of Higher Dimensional Polytopes in Chemical, Physical, and Biological Systems, (Hardcover)
Save withShipping, arrives in 3+ daysKeeping the Praying Mantis: Mantodean Captive Biology, Reproduction, and Husbandry (Hardcover) $63.94
 $6394current price $63.94
$6394current price $63.94Keeping the Praying Mantis: Mantodean Captive Biology, Reproduction, and Husbandry (Hardcover)
Save withShipping, arrives in 3+ daysReadable Darwin: The Origin of Species Edited for Modern Readers, (Hardcover) $43.70
 $4370current price $43.70
$4370current price $43.70Readable Darwin: The Origin of Species Edited for Modern Readers, (Hardcover)
Save withSalt Lakes: An Unnatural History, (Hardcover) $31.99
 $3199current price $31.99
$3199current price $31.99Salt Lakes: An Unnatural History, (Hardcover)
Save withShipping, arrives by release date Mar 17Textbook of Arthropod Anatomy, (Paperback) $18.22
 $1822current price $18.22
$1822current price $18.22Textbook of Arthropod Anatomy, (Paperback)
Save withShipping, arrives in 3+ daysEnvironmental Physiology of Animals, (Hardcover) $92.45
 $9245current price $92.45
$9245current price $92.45Environmental Physiology of Animals, (Hardcover)
Save withShipping, arrives in 3+ daysShark Lady: The True Story of How Eugenie Clark Became the Ocean's Most Fearless Scientist (Hardcover) $7.49
 $749current price $7.49
$749current price $7.49Shark Lady: The True Story of How Eugenie Clark Became the Ocean's Most Fearless Scientist (Hardcover)
35 out of 5 Stars. 3 reviewsSave withShipping, arrives in 3+ daysOar Feet and Opal Teeth: About Copepods and Copepodologists, (Hardcover) $118.23
 $11823current price $118.23
$11823current price $118.23Oar Feet and Opal Teeth: About Copepods and Copepodologists, (Hardcover)
Save withShipping, arrives in 3+ daysGigi and the Sea Turtle (Hardcover) $24.95
 $2495current price $24.95
$2495current price $24.95Gigi and the Sea Turtle (Hardcover)
Save withShipping, arrives in 3+ daysEcological Studies Geological Approaches to Coral Reef Ecology, Book 192, (Hardcover) $132.47
 $13247current price $132.47
$13247current price $132.47Ecological Studies Geological Approaches to Coral Reef Ecology, Book 192, (Hardcover)
Save withShipping, arrives in 3+ daysGetränke untersuchen und bewerten (Paperback) $28.69
 $2869current price $28.69
$2869current price $28.69Getränke untersuchen und bewerten (Paperback)
Save withShipping, arrives in 3+ days
Customer ratings & reviews
Related pages
- Climate Change Coral Reefs
- Seashell Nature Books
- Turtle Island Indigenous
- Goldfish Anatomy
- Fish Philosophy
- Fish Encyclopedia
- Fish Identification Freshwater
- Oceans & Seas Books
- Coastal Regions & Shorelines Books
- Fisheries & Aquaculture Technology & Engineering Books
- Lakes, Ponds & Swamp Books
- River Ecosystem & Habitat Books

